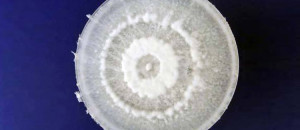
cette-decouverte-va-revolutionner-lecologie-ce-champignon-digere-totalement-le-plastique-une

Des éoliennes via Shutterstock
Des éoliennes via Shutterstock Bonne nouvelle pour la planète. Afin de lutter contre le changement climatique et les émissions de gaz à effet de serre, la Suède envisage de se passer entièrement des combustibles fossiles polluants. Son souhait : les remplacer par des énergies renouvelables en utilisant les ressources naturelles telles que le Soleil, le vent ou encore les chutes d’eau. SooCurious vous éclaire sur cette transition énergétique ambitieuse et courageuse.
Le Premier ministre suédois Stefan Löfven l’a annoncé : « La Suède sera l’un des premiers États sans énergies fossiles dans le monde. » Déterminé, le pays veut protéger ses habitants face aux effets du dérèglement climatique et agir de façon concrète pour notre planète. Cette transition énergétique est aussi un excellent moyen pour montrer l’exemple aux autres nations, et particulièrement aux mauvais élèves en termes d’environnement. D’ailleurs aujourd’hui, près de 2/3 de l’électricité de la Suède est déjà générée à partir de ressources non fossiles, provenant principalement de l’énergie hydroélectrique et du nucléaire.
Pour mettre en place cette transition audacieuse, la Suède consacrera près de 500 millions d’euros de son budget de l’année 2016 au développement des énergies renouvelables. Le budget alloué au photovoltaïque a fait un bond de 800 %, soit 42 millions d’euros par an entre 2017 et 2019. Si le gouvernement n’a pour le moment pas avancé de date butoir, la capitale du pays, Stockholm, a pour objectif de s’alimenter en électricité 100 % via les énergies renouvelables d’ici 2050.
En partie financé par l’augmentation des taxes sur le pétrole et le diesel, ce budget sera principalement dédié à la recherche de solutions de stockage des énergies renouvelables, à la rénovation énergétique des bâtiments, au développement d’un réseau électrique intelligent (smart grids), de véhicules non polluants et d’un réseau de bus écologiques.
Dans un même temps, le pays scandinave ferme peu à peu ses centrales nucléaires, trop anciennes puisqu’elles datent des années 1970-80. Trop coûteux à maintenir en état, ces sites ne seront pas remplacés.
La Suède n’est pas le seul pays à vouloir s’affranchir des combustibles fossiles et à profiter des ressources naturelles comme l’eau de pluie, le vent ou le soleil. Ainsi, le Costa Rica a réussi à s’alimenter en électricité pendant 75 jours d’affilée uniquement grâce à ses énergies renouvelables. De son côté, Hawaï souhaite devenir le premier État américain à s’approvisionner en électricité entièrement via ses ressources naturelles d’ici 2045, en utilisant notamment la force de ses vagues si célèbres.
Néanmoins, l’un des principaux enjeux de cette transition énergétique réside dans le fait que pour l’instant on ne sait pas encore comment stocker de façon rentable l’énergie produite. Car soumis aux conditions météorologiques, le soleil et le vent sont des sources d’énergie intermittentes. Il est donc nécessaire de trouver une solution pour les emmagasiner et éviter d’avoir besoin d’utiliser des sources d’alimentation d’appoint plus ou moins polluantes telles que le charbon, le nucléaire, le pétrole ou encore le gaz. Voilà l’un des défis que la Suède devra relever si elle souhaite en finir avec les combustibles fossiles une bonne fois pour toutes.
La Suède est vraiment un pays extraordinaire et très progressiste ! À la rédaction, nous sommes enthousiasmés par ce plan écologique et nous espérons que cette nation réussira à relever ce challenge ambitieux, nécessaire pour préserver notre planète et réduire les émissions de gaz à effet de serre. Si vous êtes intéressé par le développement durable, découvrez ces éoliennes novatrices sans pales capables d’éviter la mort de millions d’oiseaux. Et vous, aimeriez-vous que votre pays se passe entièrement des combustibles fossiles et fonctionne uniquement grâce aux énergies renouvelables ? Ou pensez-vous plutôt qu’il est préférable et plus sûr de s’alimenter en électricité via les centrales nucléaires ?